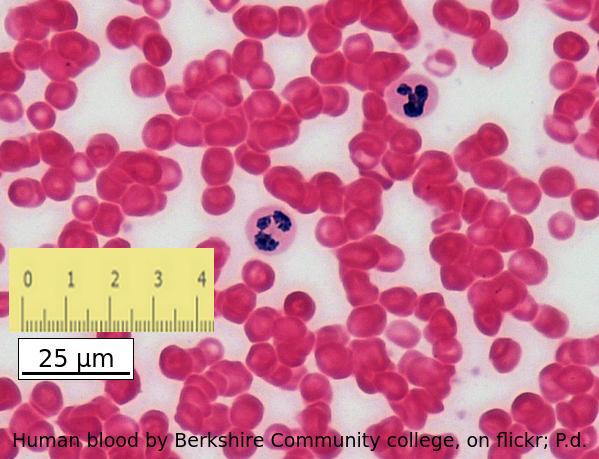
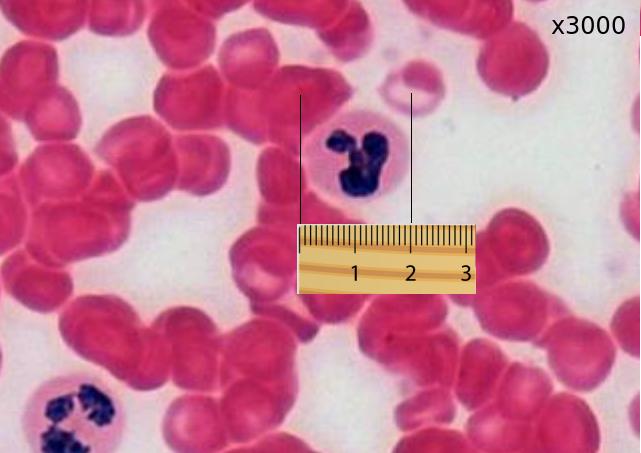

- Essentials - quick revision through the whole topic
- Summary list for 1.1 Introduction to cells
- Mindmaps
- Skills video tutorial on calculating size
- Model answer
- Model answer
- Model answer
- Model answer
- Multiple Choice questions
- 1.1 Intro to cells quiz 1/1
- 1.1 Intro to cells (2) 1/1
Learn the biological vocabulary for 1.1 Introduction to cells and test yourself using these flash cards.
Summary list for 1.1 Introduction to cells
Cell theory
- According to cell theory, living organisms are composed of cells.
- Organisms consisting of only one cell carry out all functions of life in that cell, e.g. Paramecium, Chlorella.
- Identifying the characteristics of living things (Mr H. Gren - metabolism, response, homeostasis, growth, reproduction, excretion & nutrition).
- Surface area to volume ratio is important in the limitation of cell size.
- Multicellular organisms have properties that emerge from the interaction of their cellular components, (Emergent properties).
- Specialised tissues can develop by cell differentiation in multicellular organisms.
- Differentiation involves the expression of some genes and not others in a cell.
- Stem cells can divide and differentiate along different pathways in embryonic development which makes stem cells useful for therapeutic uses (e.g. Stargardt's disease).
- There are ethical concerns about the use of embryo stem cells.
Calculating magnification and size
- Calculate the magnification of an electron microscope image from a scale bar.
- Calculate specimen size using a scale bar.
- Calculate specimen size using magnification.
Mindmaps
These diagrams summarise the main sections of topic 1.1.
Test if you can draw something like these concept maps from memory.
Can you ask several questions about the points using command terms, e.g List, Describe, Outline, Explain,
Skills video tutorial on calculating size
How to calculate the size of a cell using the scale bar.
Calculating cell size using a scale bar from David Faure on Vimeo.
This is a tricky structured question which brings together several aspects of the topic 1.1
Explain the origins of multicellular organisms and its biological significance. [5]
........................................................................ ..................................................................
........................................................................ ..................................................................
........................................................................ ..................................................................
........................................................................ ..................................................................
........................................................................ ..................................................................
Try to write an answer first then compare your answer with the model answer shown below, and explained in the video.
[Many thanks to Catarina Gouveia, St. Dominic's International School, Portugal, for this question and mark scheme]
Multiple Choice questions
This quiz contains a set of multiple choice questions covering the topic.
Explanations of each answer are displayed after you click to check the answer(s).
START QUIZ!
Click the '+' symbol to open the next quiz.
Drag and drop activities
Test your construction of biological explanations using the drag and drop questions below.
The multicellular nature of many organisms.
Drag and drop the correct term into the gap to describe differentiation.
functions proteins tissues differentiation gene expression types stem
In a multicellular organism, there are specialised that develop from cells by . Differentiation involves altering gene , genes that code for needed for cell development are expressed in the cells, hence the cells have varied due to the of protein synthesised.
Correct terminology is needed to discuss cell development.
Click the '+' symbol to open the next explanation.
How much of Introduction to cells 1.1 have you understood?


















The image shows a range of different cell types in the leaf of a Yucca plant.